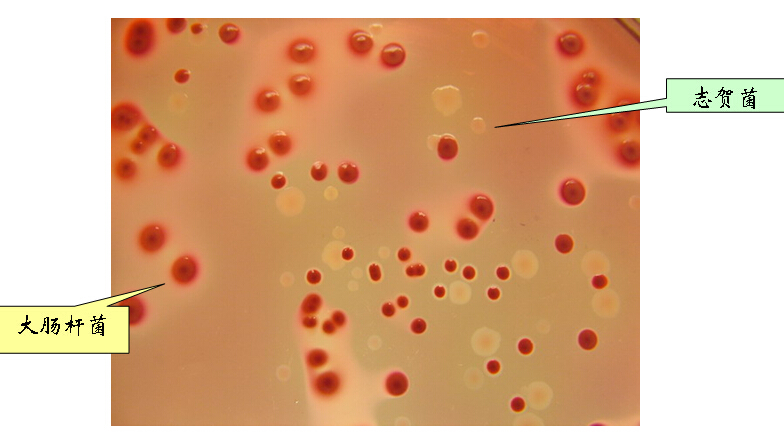
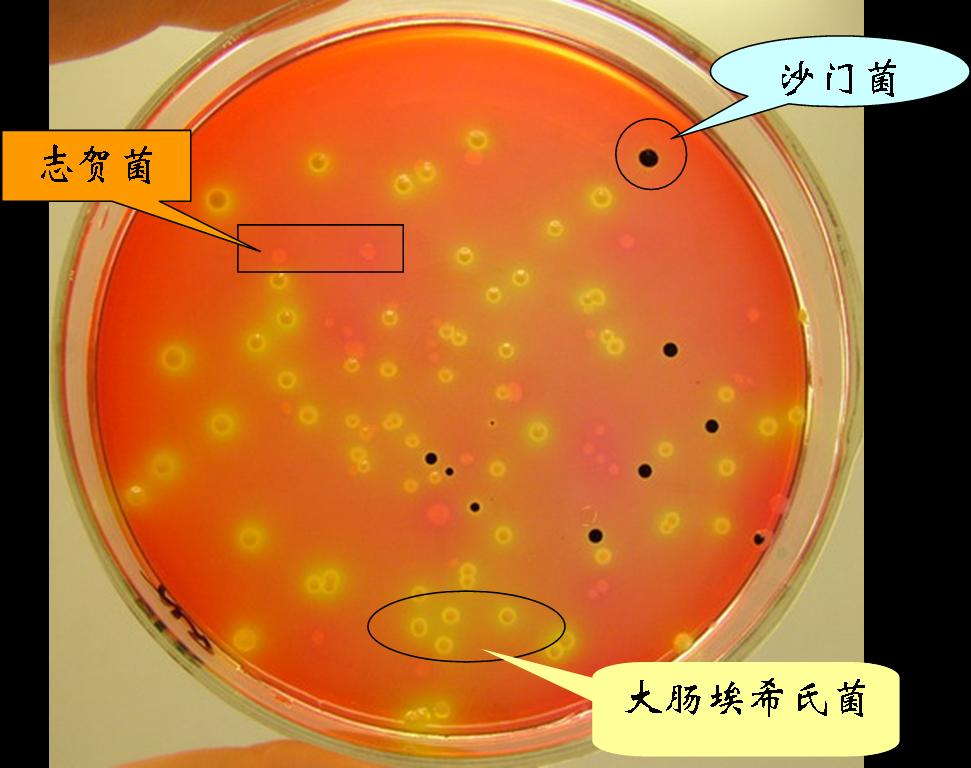

海博微信公众号
海博微信公众号
 海博天猫旗舰店
海博天猫旗舰店


 海博微信公众号
海博微信公众号
 海博天猫旗舰店
海博天猫旗舰店




麦康凯琼脂:是一种弱抑制性培养基,其抑制成分主要是胆盐,对革兰氏阳性菌的抑制作用较弱,适用于杂菌污染不严重的样品的志贺菌分离。
志贺菌的菌落形态:无色、透明、光滑、湿润、边缘整齐、圆形 。菌落大小约2~3mm。变形杆菌因不分解乳糖,其菌落形态与志贺菌相似。
XLD琼脂:培养基中含有去氧胆酸钠作指示剂,在该浓度下的去氧胆酸钠也同时作为大肠埃希氏菌的抑制剂 ,而不影响沙门菌属和志贺菌属的生长。
上一篇:单增李斯特菌的生化反应



